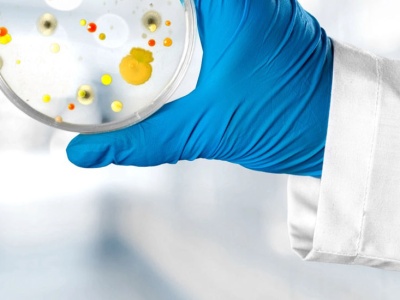
Czasem potrzeba szczęścia. Oto jak przypadek zmienił historię

Możesz mieć ekspercką wiedzę i warsztat laboratoryjny, ale czasem i tak pomóc ci może zwykły przypadek. Takich w historii ludzkości mieliśmy całkiem sporo.
źródło: https://antyweb.pl/czasem-potrzeba-szczescia-oto-jak-przypadek-zmienil-historie
dodano: 13-09-2025 11:43:08
Inne znaleziska:
Zupa jagodowa i retro ozdoby– jak aktorzy „Barw szczęścia” spędzają Święta
Zupa jagodowa i retro ozdoby– jak aktorzy „Barw szczęścia” spędzają Święta
W studiu „Pytania na śniadanie” zjawiły się gwiazdy serialu „Barwy szczęścia”, aby wziąć w nietypowym wyzwaniu. Michalina Robakiewicz, Jasper Sołtysiewicz i Jakub Dmochowski mieli za zadania ubrać choinkę przy pomocy retro ozdób. Prowadzący zachęcili...
tvp.pl
13-12-2025 15:12:11
13-12-2025 15:12:11
Ubierz choinkę jak najwcześniej, to dobre dla psychiki! Naukowcy przekonują, że świąteczne dekoracje...
Ubierz choinkę jak najwcześniej, to dobre dla psychiki! Naukowcy przekonują, że świąteczne dekoracje dają nam poczucie s...
Zimne i ciemne dni pod koniec roku przyczyniają się spadku nastroju. Możemy go jednak podnieść, dekorując dom na Święta. Nie warto więc odwlekać ubierania choinki do Wigilii, tylko zacząć już dziś. Naukowcy przekonują, że to sposób na większe poczuci...
stronazdrowia.pl
19-12-2025 06:05:15
19-12-2025 06:05:15
Miliony na koncie nie wystarczą. Psycholog wyjaśnia, jak działa mechanizm szczęścia
Miliony na koncie nie wystarczą. Psycholog wyjaśnia, jak działa mechanizm szczęścia
Wygrana na loterii wydaje się spełnieniem marzeń: brak problemów, pełne konto i życie "długo i szczęśliwie". Psychologia mówi jednak coś zupełnie innego. Euforia po wielkiej wygranej wygasa szybciej, niż myślisz, a poziom szczęścia wraca do...
well.pl
23-04-2026 17:40:07
23-04-2026 17:40:07
Cząstków Polski, czyli o tym jak zakończyły się neolityczne poszukiwania „wyspy szczęścia” na Mazows...
Cząstków Polski, czyli o tym jak zakończyły się neolityczne poszukiwania „wyspy szczęścia” na Mazowszu
Przez dekady sądzono, że obszar Mazowsza nie sprzyjał neolitycznej kolonizacji pierwszych rolników. Jednym z głównych argumentów był deficyt żyznych gleb, który urósł wręcz do rangi aksjomatu… Najnowsze badania dowodzą jednak, że tereny te były miejs...
archeowiesci.pl
25-05-2026 12:09:06
25-05-2026 12:09:06
Oto Młodzieżowe Słowo roku 2025! Każdy czasem szponci, fr bro
Oto Młodzieżowe Słowo roku 2025! Każdy czasem szponci, fr bro
Macie czasem wrażenie, że młodzież mówi w zupełnie innym języku? Że ich słownictwo brzmi jak szyfr, którego nie da się od razu rozszyfrować? Spokojnie – nie jesteście sami. Ja też łapię się na tym, że niektóre zwroty kompletnie mnie zaskakują, choć m...
instalki.pl
08-12-2025 22:15:08
08-12-2025 22:15:08
Sandra Kubicka zabrała głos ws. swojego szczęścia. Powody są jasne
Sandra Kubicka zabrała głos ws. swojego szczęścia. Powody są jasne
Sandra Kubicka nie kryje wielkiej radości. Choć ostatnio wokół byłej modelki pojawia się sporo kontrowersji, nie ma zamiaru zrezygnować ze swoich celów. Zapewnia, że ma głowę pełną nowych pomysłów, które już wkrótce wdroży w życie. Żona Aleksandra Mi...
pomponik.pl
20-07-2025 21:47:05
20-07-2025 21:47:05
U Grażyny z "Sanatorium" teraz pora na łzy szczęścia. "Jestem zakochana"
U Grażyny z "Sanatorium" teraz pora na łzy szczęścia. "Jestem zakochana"
Grażyna Nowicka z Krzczonowic nie znalazła szczęścia w 7. sezonie "Sanatorium miłości". Po zakończeniu zdjęć do programu wyjechała za granicę, i to właśnie tam odnalazł ją list od pewnego mężczyzny. Teraz kuracjuszka mówi wprost, że jest zakochana. C...
pomponik.pl
25-07-2025 21:15:08
25-07-2025 21:15:08
Zamówiła zapiekanki w wydaniu XXL. Do szczęścia zabrakło jednej rzeczy
Zamówiła zapiekanki w wydaniu XXL. Do szczęścia zabrakło jednej rzeczy
Zapiekanki z budki to wakacyjny klasyk, który na dobre rozgościł się w krajobrazie nadbałtyckich deptaków. Bagietka z dodatkami nie zawsze jest najtańszą opcją.
pysznosci.pl
26-07-2025 07:50:04
26-07-2025 07:50:04
Stal 300 mógł być pierwszym polskim, małym dostawczakiem. Zabrakło mu szczęścia i Mikrusa MR300
Stal 300 mógł być pierwszym polskim, małym dostawczakiem. Zabrakło mu szczęścia i Mikrusa MR300
Stal 300 mógł być pierwszym polskim, małym dostawczakiem. Zabrakło mu szczęścia i Mikrusa MR300
spidersweb.pl
27-07-2025 16:41:04
27-07-2025 16:41:04
Poważny pożar w fabryce maszyn rolniczych: „Mieliśmy dużo szczęścia w nieszczęściu”
Poważny pożar w fabryce maszyn rolniczych: „Mieliśmy dużo szczęścia w nieszczęściu”
W znanym zakładzie produkcyjnym maszyn rolniczych Strautmann w Bad Laer (powiat Osnabrück, Dolna Saksonia) wybuchł pożar w hali lakierni. Ogień spowodował wielogodzinną akcję gaśniczą, a straty są znaczne. Teraz ustalono przyczynę zdarzenia. Dyrektor...
cenyrolnicze.pl
20-08-2025 13:23:08
20-08-2025 13:23:08